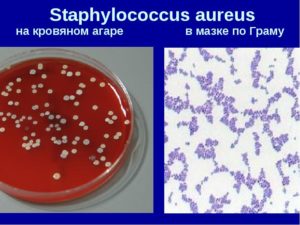
image
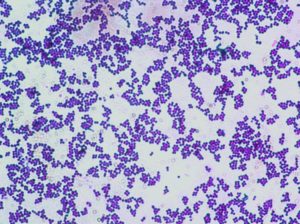
image

Мазок из зева на флору: что показывает анализ на чувствительность к антибиотикам и подготовка к нему, расшифровка результатов и их норма
Для определения причин развития болезней верхних дыхательных путей берут мазок из зева – этот метод диагностики позволит выявить тип возбудителя инфекционных, воспалительных процессов.
Чтобы анализ был точным, нужно правильно подготовиться к забору биологического материала.
Показания к процедуре
Мазок берут, чтобы изучить состав микрофлоры носоглотки, выявить возбудителя патологии, его чувствительность к антибиотикам.
В каких случаях назначают мазок:
- длительный насморк, который не проходит более 7 дней;
- аллергия;
- частые рецидивы фарингита, тонзиллита, ларингита;
- диагностика стрептококковой ангины;
- наличие проявлений инфекций, вызванных золотистым стафилококком;
- при подозрении на дифтерию, коклюш, менингит, грибковые патологии;
- туберкулёз;
- гайморит, аденоидит;
- мононуклеоз, абсцессы.
Мазок из зева входит в состав профилактического осмотра, анализ назначают детям, посещающим учебные учреждения, медработникам, лицам, которые работают с продуктами или в дошкольных и школьных заведениях.
Мазок на определение состава микрофлоры ЛОР-органов назначают всем беременным.
Соблюдение правил подготовки к сдаче мазка во многом определяет достоверность результатов.
Правила подготовки:
- за неделю прекратите принимать антибактериальные препараты в виде таблеток;
- за 5 дней откажитесь от использования спреев, мазей, ополаскивателей с антибактериальным и антисептическим действием;
- перед забором материала из ротоглотки нельзя есть, пить, жевать жвачку, курить, при необходимости сделать анализ полости рта противопоказано чистить зубы.
За неделю до сдачи анализа прекратите приём антибиотиков
Как правильно брать мазок и зева и носа?
На достоверность анализа влияет и профессионализм медицинского персонала, при погрешностях во время взятия, хранения и транспортировки биоматериала результат бакпосева будет недостоверным.
Техника проведения процедуры:
- Пациент широко открывает рот, запрокидывает голову.
- Медсестра стерильным или одноразовым шпателем надавливает на язык, ватным тампоном собирает слизь, налёт со слизистых глотки, поверхностей миндалин.
- Полученный материал помещают в пробирку с питательным раствором, который позволяет сохранить жизнеспособность бактерий в процессе транспортировки.
- Полученный биоматериал отправляют в лабораторию, время доставки не более 2 часов.
Взятия мазка – безболезненная, но неприятная процедура, надавливание на язык может спровоцировать приступ рвоты, особенно если материал берут у ребёнка.
Перед исследованием слизистой полости носа удаляют слизь, корки, кожные покровы ноздрей смазывают медицинским спиртом. Пациент немного запрокидывает голову, стерильным тампоном проводят поочерёдно по стенкам правого и левого носовой хода. Собранные в пробирку образцы, отправляют в лабораторию.
Методики изучения биоматериала
При микроскопическом исследовании полученный биоматериал окрашивают по Грамму, изучают после обработки иммерсионными маслами. Метод позволяет выявить грамположительные, грамотрицательные бактерии, кокковую флору, коккобацилл.
Бактериологический посев – один из основных методов диагностики, поскольку каждый микроорганизм может размножиться только в определённой среде, при комфортном уровне pH и влажности, при исследовании важно соблюдать полную стерильность.
Бактериологический посев – основной вид диагностики для выявления патогенных микроорганизмов
Если обнаружен рост микрофлоры, обязательно проводят тесты на антибиотикочувствительность, многие микробы способны быстро вырабатывать иммунитет к лекарствам – на фоне неэффективной терапии развиваются тяжёлые осложнения.
Мазок-отпечаток – специфический анализ для изучения состав клеток слизистой в носу. Образец наносят на предметное стекло, подсчитывают число эозинофилов, других частиц. Исследование назначают при предрасположенности к аллергии.
При неэффективности антибактериальной терапии делают тесты на фагочувствительность. Результат позволяет подобрать бактериофаги для устранения проявлений инфекционных патологий – это современные противомикробные препараты, которые вызывают гибель только определённых видов бактерий.
Расшифровка результатов анализа
На слизистых каждого человека обитает около 50 полезных микробов, представителей сапрофитной и условно-патогенной микрофлоры, изучение отделяемого из горла и носа позволяет определить количественное соотношение и состав этиологически значимых микроорганизмов.
Список микробов
| Безопасные микроорганизмы: | Опасные микроорганизмы |
|
|
Результат вписывают в бланк, в нём указывают род, вид, количество микроорганизмов, уровень патогенности. После определения типа возбудителя проводят тесты на определение чувствительности микробов к антибактериальным средствам, бактериофагам.
Отрицательный результат свидетельствует об отсутствии грибков и болезнетворных бактерий, это означает, что инфекция имеет вирусное происхождение. Положительный результат наблюдается при наличии опасных микроорганизмов, или активном росте представителей условно-патогенной микрофлоры.
По времени бактериологическое исследование занимает 5–7 дней, в экстренных случаях делается экспресс-тест для выявления антигенов к бактериям, грибкам, результат можно получить уже через полчаса.
О чём говорят повышенные показатели
Наличие большого количества грибков и бактерий в мазке – признак развития ЛОР-заболеваний, каждый микроорганизм провоцирует определённые патологии.
Превышение нормы стафилококков наблюдается чаще всего у детей
Какие болезни вызывают патогенные микроорганизмы:
- стафилококки – фарингит, тонзиллит, гингивит, синусит, активный рост бактерий чаще всего наблюдается у детей и людей преклонного возраста;
- стрептококки – ангина, скарлатина, синусит;
- грибки рода кандида – кандидоз ротовой полости, нередко сопровождается осложнениями, которые затрагивают органы дыхательной системы;
- пневмококки, нейссерии – воспаление лёгких, бронхит, отит среднего уха, остеомиелит, болезни верхних дыхательных путей, ротоглотки;
- дифтерийная коклюшная палочка, в норме бактерии в мазке отсутствуют, при положительном результате определяют уровень концентрации микробов, чтобы сделать заключение о степени развития патологии;
- гемолитический стрептококк – тяжёлые формы ангины, которые практически всегда дают осложнения на сердце.
При показателях более 10*5–10*7 КОЕ/мл вероятность развития воспалительных, инфекционных, гнойных процессов максимальная. Сливной результат – очень высокое содержание патогенных микробов, их количество невозможно посчитать, наблюдается при тяжёлых и запущенных формах заболеваний, требуется срочная антибактериальная терапия.
Мазок из носоглотки – эффективный метод диагностики заболеваний ЛОР-органов, определяет тип возбудителя патологического процесса, стадию развития болезни, позволяет подобрать эффективные методы терапии и снизить риск развития осложнений.
Мазок из зева и носа: понятие, когда и как делают, расшифровка

Мазок из зева берут для проведения стандартного бактериологического исследования с целью изучения микробного состава и количественного соотношения микрофлоры носоглотки.
Это метод лабораторной диагностики, позволяющий выявить возбудителей инфекционно-воспалительных заболеваний верхних отделов респираторного тракта.
Для определения этиологии инфекции необходимо провести бактериологическое исследование отделяемого носа и зева на микрофлору.
Специалисты направляют больных с хроническим ринитом, тонзиллитом и фарингитом в микробиологическую лабораторию, где стерильным ватным тампоном отбирают биоматериал из носа и зева и проводят его исследование. По результатам анализа специалист определяет возбудителя патологии и его чувствительность к антибиотикам.
Причины и цели взятия мазка на микрофлору из зева и носа:
- Диагностика ангины, вызванной бета-гемолитическим стрептококком и приводящей к развитию тяжелых осложнений — гломерулонефрита, ревматизма, миокардита.
- Наличие в носоглотке золотистого стафилококка, провоцирующего образование фурункулов на коже.
- Бактериологический посев клинического материала при воспалении носоглотки проводится с целью исключения дифтерийной инфекции.
- Подозрение на менингококковую или коклюшную инфекцию, а также респираторные недуги.
- Диагностика стенозирующего ларингита, мононуклеоза, абсцессов, расположенных рядом с миндалинами, включает однократное проведение анализа.
- Лица, контактные с инфекционным больным, а также дети, поступающие в детский сад или школу, проходят профилактическое обследование с целью выявления бактерионосительства.
- Полное обследование беременных женщин включает взятие мазка из зева на микрофлору.
- Мазок из зева и носа на стафилококк с профилактической целью сдают все медицинские работники, воспитатели детских садов, повара и продавцы продуктовых магазинов.
- Мазок из зева для определения клеточного состава отделяемого. Исследуемый материал наносят на специальное предметное стекло. Под микроскопом врач-лаборант подсчитывает количество эозинофилов и прочих клеток в поле зрения. Проводится исследование для определения аллергической природы заболевания.
В баклабораторию направляют больных для исследования материала из носоглотки с целью исключения или подтверждения конкретной инфекции. В направлении указывают микроорганизм, наличие которого необходимо подтвердить или опровергнуть.
Микрофлора носоглотки
На слизистой оболочке зева и носа обитает множество микроорганизмов, составляющих нормальную микрофлору носоглотки. Исследование отделяемого горла и носа показывает качественное и количественное соотношение микробов, обитающих в данном локусе.
Типы микроорганизмов, обитающих на слизистой носоглотки у здоровых людей:
- Бактероиды,
- Veillonella,
- Escherichia coli,
- Branhamella,
- Pseudomonas,
- Streptococcus matans,
- Neisseria meningitides,
- Klebsiella pneumonia,
- Эпидермальный стафилококк,
- Зеленящий стрептококк,
- Неболезнетворные нейссерии,
- Дифтероиды,
- Коринебактерии,
- Candida spp.,
- Haemophilis spp.,
- Actinomyces spp.
При патологии в мазке из зева и носа можно обнаружить такие микроорганизмы:
- Бета-гемолитический стрептококк группы А,
- Пневмококк,
- S. aureus,
- Коринобактерии дифтерии,
- Haemophilis influenzae,
- Neisseria meningitidis,
- Candida albicans,
- Бордетелла,
- Листерия,
- Branhamella catarrhalis,
- Acinetobacter baumannii,
- Энтеробактерии.
Подробнее о встречающемся в мазке стафилококке, его патогенности и стафилококковой инфекции рекомендуем почитать по ссылке.
Чтобы результаты анализа были максимально достоверными, необходимо правильно отобрать клинический материал. Для этого следует подготовиться.
За две недели до забора материала прекращают прием системных антибиотиков, а за 5-7 суток рекомендуют перестать использовать антибактериальные растворы, ополаскиватели, спреи и мази для местного применения. Сдавать анализ следует натощак. Перед этим запрещено чистить зубы, пить воду и жевать жвачку. В противном случае результат анализа может оказаться ложным.
Мазок из носа на эозинофилы сдают также натощак. Если человек поел, необходимо подождать как минимум два часа.
Взятие материала
Чтобы правильно взять материал из зева, пациенты откидывают голову назад и широко раскрывают рот. Специально обученный персонал лаборатории шпателем прижимает язык и собирает отделяемое глотки специальным инструментом – стерильным ватным тампоном. Затем извлекает его из полости рта и опускает в пробирку.
Пробирка содержит специальный раствор, которой предотвращает гибель микробов во время транспортировки материала. Пробирку необходимо доставить в лабораторию в течение двух часов с момента забора материала. Взятие мазка из горла – процедура безболезненная, но неприятная.
Прикосновение ватного тампона к слизистой глотки может спровоцировать рвотные позывы.
Чтобы взять мазок из носа, необходимо усадить пациента напротив и слегка запрокинуть ему голову. Перед анализом необходимо очистить нос от имеющейся слизи. Кожу ноздрей обрабатывают 70% спиртом.
Стерильный тампон вводят поочередно сначала в один, а затем в другой носовой ход, проворачивая инструмент и плотно прикасаясь к его стенкам.
Тампон быстро опускают в пробирку и направляют материал на микроскопическое и микробиологическое исследование.
Микроскопическое исследование
Исследуемый материал наносят на предметное стекло, фиксируют в пламени горелки, окрашивают по Граму и изучают под микроскопом с иммерсионным маслом. В мазке обнаруживают грамотрицательные или грамположительные палочки, кокки или коккобациллы, изучают их морфологические и тинкториальные свойства.
Микроскопические признаки бактерий — важный диагностический ориентир. Если в мазке находятся грамположительные кокки, расположенные скоплениями, напоминающими гроздья винограда, предполагают, что возбудителем патологии является стафилококк.
Если кокки окрашены по Граму положительно и располагаются в мазке цепочками или парами, возможно это стрептококки; грамотрицательные кокки — нейсерии; грамотрицательные палочки с закругленными концами и светлой капсулой — клебсиеллы, мелкие грамотрицательные палочки — эшерихии, синегнойные палочки.
Дальнейшее микробиологическое исследование продолжают с учетом микроскопических признаков.
Посев исследуемого материала
Каждый микроорганизм растет на своей «родной» среде с учетом рН и влажности. Среды бывают дифференциально-диагностическими, селективными, универсальными. Их основное предназначение – обеспечение питания, дыхания, роста и размножения бактериальных клеток.
Посев исследуемого материала необходимо проводить в стерильном боксе или ламинарном шкафу. Медработник должен быть одет в стерильную одежду, перчатки, маску и бахилы. Это необходимо для соблюдения стерильности в рабочей зоне. В боксе следует работать молча, аккуратно, обеспечивая личную безопасность, поскольку любой биологический материал считается подозрительным и заведомо заразным.
Мазок из носоглотки засевают на питательные среды и инкубируют в термостате. Спустя несколько суток на средах вырастают колонии, имеющие различную форму, размер и цвет.
Существуют специальные питательные среды, которые являются селективными для конкретного микроорганизма.
- Основной средой для микробов зева и носа является кровяной агар. Это высокочувствительная среда, содержащая питательные вещества для сапрофитных и патогенных бактерий. Пневмококки и золотистый стафилококк продуцируют гемолизины и вызывают гемолиз эритроцитов. Гемолитическая активность микробов — основной фактор патогенности, которым обладает большинство болезнетворных бактерий. Характер роста, цвет и зона гемолиза отличаются у микробов разных родов и видов.
- Среда Сабуро или тиогликолевая среда являются универсальными и подходят для широкого круга микробов.
- Желточно-солевой агар — элективная среда для выращивания стафилококков.
- Агар с гретой кровью – шоколадный агар. Это неселективная, обогащенная питательная среда, применяемая для выращивания патогенных бактерий. На этой среде растут гонококки, гемофильная палочка и возбудители гнойных бактериальных менингитов.
- Среда Эндо – дифференциально-диагностическая среда для культивирования энтеробактерий.
- Энтерококкагар — питательная среда для выделения энтерококков.
Материал втирают тампоном в среду на небольшой площадке размером 2 кв. см., а затем с помощью бактериологической петли штрихами рассевают по всей поверхности чашки Петри. Посевы инкубируют в термостате при определенной температуре. На следующий день посевы просматривают, учитывают количество выросших колоний и описывают их характер.
Пересевают отдельные колонии на селективные питательные среды для выделения и накопления чистой культуры. Микроскопическое изучение чистой культуры позволяет определить размер и форму бактерии, наличие капсулы, жгутиков, спор, отношение микроба к окрашиванию.
Идентифицируют выделенные микроорганизмы до рода и вида, при необходимости проводят фаготипирование и серотипирование.
Результат исследования
Результат исследования врачи-микробиологи выписывают на специальном бланке. Для расшифровки результата мазка из зева требуются значения показателей.
Название микроорганизма состоит из двух латинских слов, обозначающих род и вид микроба. Рядом с названием указывают количество бактериальных клеток, выраженное в особых колониеобразующих единицах.
После определения концентрации микроорганизма переходят к обозначению его патогенности – «флора условно-патогенная».
У здоровых людей на слизистой оболочке носоглотки живут бактерии, выполняющие защитную функцию. Они не доставляют дискомфорта и не вызывают развития воспаления. Под воздействием неблагоприятных эндогенных и экзогенных факторов количество этих микроорганизмов резко увеличивается, что приводит к развитию патологии.
В норме содержание сапрофитных и условно-патогенных микробов в носоглотке не должно превышать 103 – 104 КОЕ/мл, а патогенные бактерии должны отсутствовать.
Определить патогенность микроба и расшифровать анализ может только врач, обладающий специальными навыками и знаниями.
Доктор определит целесообразность и необходимость назначения больному противовоспалительных и антибактериальных препаратов.
После выявления возбудителя патологии и его идентификации до рода и вида переходят к определению его чувствительности к фагам, антибиотикам и противомикробным препаратам. Лечить заболевание горла или носа необходимо тем антибиотиком, к которому выявленный микроб максимально чувствителен.
результатов исследования мазка из зева
Варианты результатов исследования мазка из зева:
- Отрицательный результат посева на микрофлору – возбудители бактериальной или грибковой инфекции отсутствуют. В этом случае причиной патологии являются вирусы, а не бактерии или грибы.
- Положительный результат посева на микрофлору – наблюдается рост патогенных или условно-патогенных бактерий, способных вызвать острый фарингит, дифтерию, коклюш и прочие бактериальные инфекции. При росте грибковой флоры развивается кандидоз полости рта, возбудителем которого являются биологические агенты 3 группы патогенности – дрожжеподобные грибы рода Candida.
Микробиологическое исследование отделяемого зева и носа на флору позволяет определяют вид микробов и их количественное соотношение. Все патогенные и условно-патогенные микроорганизмы подлежат полной идентификации. Результат лабораторной диагностики позволяет врачу правильно назначить лечение.
: о мазке и стафилококке в нем, доктор Комаровский
Мнения, советы и обсуждение:
Золотистый стафилококк в горле у взрослых и детей: причины, признаки, диагностика и методы лечения

По статистике, более чем у 50% здоровых людей есть золотистый стафилококк, при этом они не ощущают дискомфорта и не обращаются к врачу. Если иммунитет в порядке, микроорганизм, который считается патогенным и очень опасным, не требует медицинского вмешательства. Но при стечении нескольких неблагоприятных факторов развивается воспаление, и в этом случае необходима терапия.
Способы заражения
Здоровый человек становится носителем стафилококковой инфекции в горле тогда, когда вдыхает воздух с находящимися в нем бактериями. Если это происходит на фоне (или после) длительного лечения антибиотиками, ослабленной иммунной системы, гормональных нарушений, вирусной инфекции или эндокринного заболевания, развивается воспаление.
В горле образуется гнойный налет, мягкие ткани миндалин начинают разрушаться и отмирают, может развиться тонзиллит и другие заболевания. Если врач диагностирует стафилококк горла, лечение нужно проводить не только антибиотиками, но и другими таблетками. Также нужно учитывать, что микроб может быть устойчив к препаратам, которые пациент принимал ранее.
Существует несколько способов заражения (первыми указаны те, что встречаются наиболее часто):
· Контактный. Пренебрежение правилами гигиены приводит к тому, что бактерии стрептококки и стафилококки попадают в гортань с предметов обихода, детских игрушек, посуды. Например, подержавшись за дверную ручку, на которой есть бактерии, и поднеся руки ко рту, человек рискует заразиться.
· Воздушно-капельный. Находясь в одном помещении с больным, здоровый человек вдыхает воздух, в котором есть бактерии, и через некоторое время обнаруживает симптомы стафилококка в горле.
Стафилококк ауреус в горле может появиться даже после того, как человек вдохнет воздух с некоторым количеством микроорганизмов. Доказано, что микроб может длительное время обитать в воздухе, оставаясь жизнеспособным.
Симптомы развития стафилококковой инфекции
При стафилококке в горле могут развиться самые разные заболевания, но чаще всего врачи диагностируют стафилококковый ларингит, фарингит или тонзиллит.
Признаки, характерные для стафилококкового ларингита:
· воспаление слизистых гортани, которое может сопровождаться трахеитом;
· першение и сухость в горле;
· болезненное глотание;
· гнойные пробки;
· осиплость или полная потеря голоса;
· сухой кашель, через несколько дней сменяющийся влажным, с обильным выделением мокроты;
· повышение температуры до 38,1—38,5 °C (иногда выше).
Признаки стафилококкового фарингита (диагностируется примерно в 5 случаях из 100):
· повышенная температура тела (37,5 °C и выше);
· вязкий слизистый налет на стенках горла;
· першение, вызывающее сухой кашель;
· отечность мягких тканей гортани;
· слабость, общее ухудшение самочувствия;
· боль в горле, которая усиливается при глотании;
· сиплый голос.
Симптомы, характерные для стафилококкового тонзиллита:
· резкое повышение температуры (до 39—40 °C);
· боль в горле, переходящая на виски, мышцы шеи, уши;
· головная боль, слабость, головокружение, слезотечение;
· скопление беловато-желтого налета на слизистых гортани, дужках и язычке (легко удаляется);
· образование гноя на миндалинах;
· гиперемия слизистых оболочек миндалин и горла;
· озноб;
· увеличение лимфоузлов в области шеи;
· сильная боль при глотании;
· потеря аппетита.
Современные методы диагностики
До того как лечить стафилококк в горле, кроме внешнего осмотра, необходимо сдать анализы. Сейчас для постановки диагноза используются серологический и микробиологический методы. Микробиологический анализ проводится так: у пациента берут мазок из горла, материал помещают в питательную среду, имеющую способность к окрашиванию.
Спустя сутки анализируют результаты посева. Если пигмент желтого цвета, значит, у человека обычный стафилококк в зеве, и лечение не требуется. В таком случае нужно искать истинную причину ухудшения самочувствия, — это может быть пневмония или другое заболевание.
При наличии стафилококка в горле симптомы проявляются по-другому: бактерии, попав в питательную среду, образуют колонии диаметром до 4 мм, имеющие выпуклую форму и оранжевый, белый или желтый цвет. Если нет времени ждать, пока бакпосев даст результаты, выявить болезнь может при помощи коагулазного теста.
Его плюс в том, что результаты можно узнать уже через 4 часа, но если они будут отрицательными, время ожидания продлевается еще на 24 часа.
Серологический метод заключается в том, что на микробы воздействует стафилококковый бактериофаг. Их существует несколько групп, и каждая воздействует только на определенные виды патогенных микроорганизмов. Из-за невысокой точности (болезнь выявляется примерно в 60% случаев) сейчас этот способ применяется редко.
Есть допустимая норма содержания стафилококков в организме. Она выражается в микроскопических числах, которые ни о чем не скажут обычному человеку.
Но пациент должен знать, что есть разница между стафилококком и стафилококковой инфекцией. В первом случае опасности нет, во втором — есть, и очень серьезная.
Начинать лечение нужно немедленно, потому что появление инфекции свидетельствует о слабом иммунитете, и это значит, что организм не справится с болезнью собственными силами.
Общие принципы лечения
Уничтожить патогенные микроорганизмы можно только путем комплексного воздействия, так как стрептококк и стафилококки могут быть образованы разными штаммами, каждый из которых обладает устойчивостью к определенной группе антибиотиков.
Кроме того, колонии стафилококка в горле у взрослых и детей выделяют вещества, нейтрализующие эффективность некоторых препаратов. Для борьбы с инфекцией применяют антистафилококковые медикаменты: анатоксины, иммуноглобулины, бактериофаги.
Результат лечения проявляется в следующем:
· укрепляется местный и неспецифический иммунитет;
· быстро заживают пораженные слизистые оболочки и мягкие ткани;
· подавляется активность болезнетворных микроорганизмов — возбудителей инфекции.
Местные антибиотики (таблетки, инъекции) помогают пациентам, у которых имеется стрептококк на миндалинах или стафилококковая инфекция в горле.
Если поражены не только ткани и слизистые гортани, но и дыхательные пути (внелегочные и внутрилегочные ветвления бронхов, трахея, бронхиолы), проводят терапию сильнодействующими противостафилококовыми медикаментами и системными антибиотиками. Полезно делать полоскания препаратами Мирамистин, Фурацилин.
Важно: покупая Мирамистин, необходимо обращать внимание на концентрацию и назначение, так как данный препарат выпускается для разных целей.
Повышают эффективность лечения физиопроцедуры:
· УФО горла;
· УФО носа;
· тубус-кварц;
· электрофорез;
· гелий-неоновый лазер;
· токи УВЧ.
Антимикробные препараты системного действия выпускаются в виде спреев, инъекционных растворов, сиропов, таблеток, суспензий, капсул. Эффективно уничтожают золотистый стафилококк в горле у ребенка препараты, устойчивые к бета-лактамазе и пенициллиназе — ферментам, синтезируемым патогенными бактериями.
Лекарства на растительной основе
Препараты, содержащие растительные компоненты, относят к группе фитоадаптогенов. Их действие направлено на повышение сопротивляемости организма различным патогенным организмам: простейшим, вирусам, микробам, грибкам.
В составе таких препаратов обычно содержатся биологически активные вещества, микроэлементы и витамины.
В результате применения растительных адаптогенов снижается риск заболеть, а у тех, кто уже страдает от развившегося инфекционного заболевания, улучшается общее состояние.
Как проявляется действие лекарств:
· снижается утомляемость;
· улучшается аппетит;
· приходит в норму самочувствие;
· исчезает боль в горле;
· проходит отечность миндалин;
· уменьшается или полностью исчезает гиперемия.
Если до этого были другие признаки интоксикации стафилококком, они также уменьшаются. Растительные препараты полезны тем, что они способствуют скорейшему выздоровлению, предотвращают обострение болезни и снижают риск рецидива в дальнейшем.
Наиболее эффективные и недорогие фитоадаптогены:
· аралия;
· родиола розовая;
· лимонник;
· облепиха;
· эхинацея.
Все препараты выпускаются в виде настоек и экстрактов. Что лучше принимать от золотистого стафилококка, подскажет лечащий врач.
Важно: у адаптогенов имеются противопоказания. В том числе, их нельзя принимать пациентам, у которых повышено артериальное давление.
При беременности экстракты и настои принимать не рекомендуется.
В крайнем случае, необходимо предварительно проконсультироваться с гинекологом. Подобные средства повышают давление, при этом возможны неблагоприятные последствия как для плода, так и для самой женины.
Также нежелательно давать растительные адаптогены детям: возможны побочные эффекты в виде бессонницы, отечности слизистых, кожного зуда, крапивницы.
Иммуностимулирующие препараты
Лечить золотистый стафилококк в горле у ребенка и у взрослого необходимо с использованием медикаментов, укрепляющих защитные силы организма. К иммуностимуляторам (иммуномодуляторам) относят медикаменты на растительной или животной основе, которые способствуют восстановлению нормального функционирования защитной системы организма.
Когда в гортани человека обнаруживается стафилококк или стрептококк, назначают препараты, влияющие на синтез иммуноглобулинов. Такое лечение направлено на то, чтобы купировать воспалительный процесс и не допустить рецидива после выздоровления.
В медицинской практике для того, чтобы победить стафилококк и стрептококк в горле, применяют следующие иммуномодулирующие лекарства:
· Тактивин;
· Рибомунил;
· Полудан;
· ИРС-19.
Лечиться необходимо не только до исчезновения симптомов воспаления, но и в течение месяца после того, как наступит выздоровление. Такие препараты следует принимать как больным в рамках терапии при стафилококке горле, так и всем, кто страдает вторичным иммунодефицитом. Иммуностимуляторы значительно снижают риск развития инфекционных заболеваний.
Лечение народными средствами
К числу эффективных методов относят фототерапию.
Но чтобы точно узнать, как вылечить больное горло и не навредить себе, предварительно нужно проконсультироваться с практикующим фитотерапевтом, которым знает, что такое золотистый стафилококк aureus.
Экспериментировать с народными средствами не рекомендуется. Все же можно назвать перечень эффективных трав и плодов, которые помогают вылечить стафилококк в горле у детей и взрослых:
· мякоть абрикоса (принимать в виде пюре утром и вечером);
· плоды черной смородины (есть натощак в свежем виде);
· ванны с яблочным уксусом (50 г на ванну);
· настойка прополиса (использовать для полоскания)
· настой из смеси лекарственных трав (купить в аптеке и принимать по инструкции).
Лечение стафилококка у беременных и детей
Учитывая, что ослабленный организм хуже сопротивляется инфекции, при одинаковых обстоятельствах стафилококк в горле у ребенка или беременной женины появится с большей вероятностью, чем у остальных категорий пациентов.
Однако лечить детей и будущих мам сложнее из-за большого количества противопоказаний и ограничений. Выбирая, чем лечить стафилококк, врач должен учитывать и индивидуальные особенности каждого человека.
Методы борьбы с инфекцией в горле у детей подбирает педиатр, а схема лечения беременной женщины подбирается врачом-инфекционистом, при этом может потребоваться участие гинеколога, который ведет беременность.
Как лечиться тем, кто является носителем стафилококка?
Инфекция, развиваясь, способна повлечь за собой серьезные осложнения, и в этом кроется ее главная опасность. Бактерии продуцируют опасные токсины, которые накапливаются в мышечных тканях, почках, легких, печени и селезенке.
При наличии микробов в горле лечение должно быть своевременным, иначе может начаться заражение крови, способное привести к летальному исходу.
Лечение стафилококка в горле не понадобится, если еще до того, как разовьется воспаление, человек будет делать следующее:
· В течение недели закапывать в нос капли «Стафилококковый бактериофаг», по 4 капли в каждую ноздрю;
· 2 раза в день, на протяжении 10 дней, впрыскивать двойную дозу лекарства «ИРС-19» в каждую ноздрю;
· В течение 30 дней пить по 1 капсуле препарата «Бронхо-мунал» (утром, до еды).
Рекомендованная продолжительность терапевтического курса, которой обычно хватает, чтобы избавиться от инфекции — 1 месяц.
Затем необходимо сделать контрольный бакпосев, чтобы убедиться, что лечение золотистого стафилококка в горле дало результаты. Если носительство патогенных микроорганизмов не выявлено, можно начать принимать иммуностимуляторы.
При наличии микробов в количестве, превышающем норму, следует сделать инъекцию стафилококкового анатоксина.
Вывод: быстро и эффективно вылечить золотистый стафилококк возможно только при взаимодействии с врачом и выполнении всех рекомендаций. Применять рецепты народной медицины не возбраняется, но они должны выступать не заменой полноценной терапии, а дополнением к ней.
Стафилококк ауреус в горле: лечение, норма, мозок из зева
В микрофлору совершенно здорового человека попадают стафилококки, которые относятся к неподвижным грамположительным бактериям. Они локализуются на коже, в носовой и ротовой полости.
Бактерии способны вырабатывать токсины, ферменты, которые разрушают человеческий организм. Поэтому к их появлению следует относиться с опаской, своевременно идти к специалисту для грамотной диагностики и лечения. Люди со слабой иммунной системой, новорожденные, старики являются носителями стафилококков.
Абсолютным патогенном является золотистый стафилококк (ауреус) в горле. Он, попадая во внутреннюю среду, провоцирует ряд заболеваний, поэтому важно вовремя выявить паразита в организме и назначить лечение.
Что такое стафилококк ауреус
Современная медицина насчитывает около двадцати стафилококковых микроорганизмов. Многие из них не провоцируют патологических процессов. В пределах нормы они могут располагаться на слизистых оболочках человеческого организма, не принося ему дискомфорта и вреда.
Фермент вырабатывает два вида стафилококка:
- коагулазу;
- ауреус или золотистый стафилококк.
Золотистый цвет бактерии служил ей при получении названия. Стафилококк ауреус характеризуют, как самый патогенный из всей группы. Он часто находится в горле человека, что считается нормальным явлением.
Справка: по статистическим данным до 50% являются носителями стафилококка ауреус. При небольшой численности бактерии не приносят вреда здоровью человека, иммунитет способен контролировать их функционирование, подавляя инфекцию и воспалительный процесс.
Стафилококк ауреус в зеве в большом количестве развивает патологии, снижает иммунитет.
особенность стафилококка, это его устойчивость к антибиотикам, что усложняет процесс лечения.
Специалисты назначают бактериофаги, это средства содержащие вирусы уничтожающие бактерию.
Золотистый стафилококк признан госпитальной инфекцией. Все чаще им можно заразиться в больнице. Он передается воздушно-капельным путем. Среди персонала медицинских учреждений носителем бактерии является 35% работников.
По каким признакам обнаружить болезнь
Золотистый стафилококк попадает на слизистую оболочку горла при употреблении продуктов, содержащих бактерию, при общении с носителем микроорганизма.
Кариес зубов и хронические патологии верхних дыхательных путей являются провокаторами стафилококка в глотке.
Стафилококк ауреус в горле у ребенка не вызывает удивления специалистов. Дети, изучая окружающий мир все предметы тянут в рот, на многих из которых могут находиться разные паразиты.
ВНИМАНИЕ! Зафиксированы случаи, когда малыш заражен инфекцией от мамы во время родовой деятельности или при грудном вскармливании.
Когда стафилококк ауреус в горле не вызывает патологических процессов, не стоит быть уверенным, что он безвреден. Как только иммунная система дает сбой, становиться чуть слабей обычного состояния, бактерия, активно проявляя себя, запускает в ход ряд болезней.
Золотистый стафилококк имеет свойство при длительном терапевтическом отсутствии мигрировать в суставы, легкие, сердце и другие органы человека.
Патогенная бактерия, попадая в горло или иные органы человека, не проявляет характерной для себя симптоматики. Начало инфекционного периода провоцирует простуду, ангину.
В сочетании несколько симптомов свидетельствуют о попадании стафилококка на слизистые оболочки горла:
- температура резко начинает повышаться, она может расти до 39-40°, при этом сбить ее до нормы тяжело, даже применяя нужные лекарственные препараты;
- появляется слабость, повышенная усталость, вялость, апатия к окружающему;
- пациенты жалуются на головокружение при резких движениях, после сна, во время активного физического труда;
- пропадает аппетит, даже самые любимые блюда не приносят удовольствия;
- увеличиваются лимфатические узлы, при пальпации проявляются болевые ощущения;
- горло воспаляется и краснеет;
- увеличиваются миндалины;
- при визуальном осмотре видны гнойники на слизистых горла;
- сухой кашель;
- жалобы на постоянную головную боль.
У детей наличие бактерии приводит к частым болезням. Стафилококки способны путешествовать по детскому организму вызывая поражение органов и провоцируя болезни. Новорожденные склонны к фарингиту, если бактерия превышает норму.
Бывают случаи, когда стафилококк попадает на слизистые вместе с кандидой, что усложняет протекание болезней и лечение.
Симптоматика детей немного отличается от взрослых проявлений. Малыши склонны к метеоризмам, болям в животе, расстройствам кишечника. Часто маленьких пациентов давит сухой кашель, боль при глотании пищи.
Температура тела подымается до 40 градусов, что является очень опасным для всех детских органов. Ребенок становится беспокойным, капризничает, отказывается кушать, играть, спокойно спать.
Задача родителей своевременно обращаться на консультацию к специалисту и правильно лечить свое чадо, не принося маленькому организму дискомфорта и стресса.
Необходимые анализы
Проявляет себя бактерия без специфических симптомов, поэтому обнаружить ее сразу визуально практически невозможно. Сначала начинается лечение ангины лекарственными препаратами, которые не действуют на удаление микроорганизма.
Только после грамотной диагностики специалист делает заключение и прописывает нужные медицинские препараты. Мазок из зева стафилококк ауреус обнаруживает в начальной стадии патологического процесса.
Направляет на лабораторные исследования лечащий педиатр, семейный терапевт или специалист узкого профиля отоларинголог.
Важно: если заболевание часто повторяется, пациенту требуется консультация инфекциониста и иммунолога.
Чтобы результат анализа был достоверным, перед сдачей мазка специалистами проводится беседа с пациентом.
Существуют определенные правила, которые следует соблюдать, готовясь больному к процедуре:
- несколько дней перед процедурой не полоскать горло и рот;
- не использовать спрей для горла, в составе которого имеется антибактериальные средства;
- утром не кушать и не употреблять жидкость;
- кушать за 8-9 часов до сдачи анализа, не позже.
Желательно перед процессом меньше говорить, если есть возможность не общаться вообще. Придерживаясь советов результаты точные, доктору легче назначить правильное лечение, которое за короткий период времени покажет эффективный результат.
Диагностируют наличие инфекции несколькими методами:
- Микроскопический способ проводят чаще всего. Полученные от пациента материалы специально окрашивают по методу Грама и просматривают под микроскопом. Патогенные кокки будут среди всех выделяться синим окрасом.
- «Проращивают» микроорганизмы при культуральном способе диагностики. Результаты исследования готовы по истечению нескольких дней. Данный метод при результате показывает не только наличие золотистого стафилококка, но и другие паразитирующие бактерии.
Стафилококк ауреус в горле: норма достигает 106 кое/мл. Если показатели превышают норму, требуется незамедлительное лечение, назначенное специалистом.
Как вылечить заболевание
Стафилококк ауреус в горле лечение проходит только после правильного диагностирования. Обязательно доктором назначается антибиотик, без которого с инфекцией не справиться.
Нельзя самостоятельно решать, какое антибактериальное средство лучше, потому что назначается оно в зависимости от результатов исследования.
Патогенные бактерии устойчивы ко многим антибактериальным лекарствам, наносят вред ЖКТ, по этой причине грамотно подобрать средство для эффективного лечения может только специалист имеющий опыт в данном направлении.
Если антибактериальная терапия неэффективна или невозможна по определенным причинам, пациентам рекомендуется бактериофаг, выступающий вирусом микроорганизмов. Важно знать, что эффективно действует бактериофаг на определенную группу патогенных бактерий.
Рекомендации
В сочетании с лекарственными препаратами специалисты рекомендуют полоскать горло отваром ромашки или шалфея. Полоскание разрешено только при нормальной температуре тела.
Всегда лечение болезни требует укрепления иммунитета.
Принимать комплексные витамины рекомендуют даже при отсутствии паразитирующих бактерий в весеннюю пору, когда организм требует поддержки.
Чтобы не запускать размножение бактерий важно вовремя проводить диагностику и лабораторные исследования. Обязательно этот момент учитывают при планировании материнства и на всех триместрах беременности.
